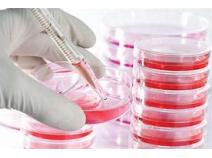

Orbis Research Present’s “Global Cell and Tissue Culture Supplies Market” magnify the decision making potentiality and helps to create an effective counter strategies to gain competitive advantage.
—
The Global Cell and Tissue Culture Supplies Market status, future forecast, growth opportunity, key market and key players. The study objectives are to present the Cell and Tissue Culture Supplies development in United States, Europe and China.
Cell culture is the process by which cells are grown under appropriate conditions. Cell tissue culture requires a suitable cell or tissue which is grown in a suitable medium under aseptic conditions along with various regulators to maintain the growth of cells.
North America dominates the global cell and tissue culture supplies market. The U.S. represents the largest market for cell and tissue culture supplies, followed by Canada, in North America. This is due to technological advancement and increasing R&D in the field of cell and tissue culture in the region. Asia is expected to experience high growth rates in the next five years in the global cell and tissue culture supplies market. This is due to increasing outsourcing of biopharmaceutical in the region. In addition, improving research infrastructure is also supporting in the growth of cell and tissue culture supplies market in the region. China and India are expected to be the fastest growing cell and tissue culture supplies markets in Asia.
In 2018, the global Cell and Tissue Culture Supplies market size was xx million US$ and it is expected to reach xx million US$ by the end of 2025, with a CAGR of xx% during 2019-2025.
Get PDF Sample copy of Cell and Tissue Culture Supplies Industry Research Report @ https://www.orbisresearch.com/contacts/request-sample/2481343
The key players covered in this study
Thermo Fisher Scientific, Inc.
BD Diagnostics.
EMD Millipore.
Corning, Inc.
Lonza Group.
…
Market analysis by product type
Media
Reagents
Sera
Contamination Detection Kits
Cryoprotective Agents
Others
Market analysis by market
Treatment of Diseases
Production of Vaccines and Antibodies
Drug Discovery
Others
Market analysis by Region
United States
Europe
China
Japan
Southeast Asia
India
Central & South America
The study objectives of this report are:
To analyze global Cell and Tissue Culture Supplies status, future forecast, growth opportunity, key market and key players.
To present the Cell and Tissue Culture Supplies development in United States, Europe and China.
To strategically profile the key players and comprehensively analyze their development plan and strategies.
To define, describe and forecast the market by product type, market and key regions.
Buy a report @ https://www.orbisresearch.com/contact/purchase/2481343
Some Points From TOC:
Chapter One: Report Overview
1.1 Study Scope
1.2 Key Market Segments
1.3 Players Covered
1.4 Market Analysis by Type
1.4.2 Media
1.4.3 Reagents
1.4.4 Sera
1.4.5 Contamination Detection Kits
1.4.6 Cryoprotective Agents
1.4.7 Others
1.5 Market by Application
1.5.1 Global Cell and Tissue Culture Supplies Market Share by Application (2018-2025)
1.5.2 Treatment of Diseases
1.5.3 Production of Vaccines and Antibodies
1.5.4 Drug Discovery
1.5.5 Others
1.6 Study Objectives
1.7 Years Considered
Chapter Two: Executive Summary
2.1 Cell and Tissue Culture Supplies Market Size
2.2 Cell and Tissue Culture Supplies Growth Trends by Regions
2.2.1 Cell and Tissue Culture Supplies Market Size by Regions (2018-2025)
2.2.2 Cell and Tissue Culture Supplies Market Share by Regions (2018-2025)
2.3 Industry Trends
2.3.1 Market Top Trends
2.3.2 Market Use Cases
Chapter Three: Key Players
3.1 Cell and Tissue Culture Supplies Revenue by Manufacturers (2018-2019)
3.2 Cell and Tissue Culture Supplies Key Players Head office and Area Served
3.3 Key Players Cell and Tissue Culture Supplies Product/Solution/Service
3.4 Date of Enter into Cell and Tissue Culture Supplies Market
3.5 Key Players Cell and Tissue Culture Supplies Funding/Investment Analysis
3.6 Global Key Players Cell and Tissue Culture Supplies Valuation & Market Capitalization
3.7 Mergers & Acquisitions, Expansion Plans
Chapter Four: Breakdown Data by Type and Application
4.1 Global Cell and Tissue Culture Supplies Market Size by Type (2018-2025)
4.2 Global Cell and Tissue Culture Supplies Market Size by Application (2017-2025)
About Us:
Orbis Research (orbisresearch.com) is a single point aid for all your market research requirements. We have vast database of reports from the leading publishers and authors across the globe. We specialize in delivering customized reports as per the requirements of our clients. We have complete information about our publishers and hence are sure about the accuracy of the industries and verticals of their specialization. This helps our clients to map their needs and we produce the perfect required market research study for our clients.
Contact Info:
Name: Hector Costello
Organization: Orbis Research
Address: 4144N Central Expressway, Suite 600, Dallas, Texas – 75204, U.S.A.
Phone: +1 (214) 884-6817; +912064101019
Website: https://www.orbisresearch.com/reports/index/global-cell-and-tissue-culture-supplies-market-size-status-and-forecast-2019-2025
Source: MarketersMedia
Release ID: 468748